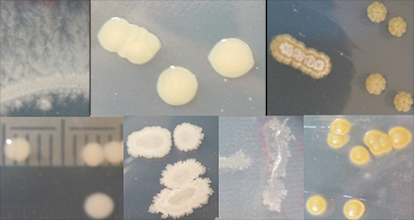
Crédit image : Claire Sergeant

Une conférence intitulée « Quel rôle pour les bactéries dans des environnements contaminés par des radioéléments ? » vous est proposée le lundi 13 juin 2022 à 14h en visioconférence, dans le cadre des Lundis de l'OHM de l'Observatoire Hommes-Milieux de Fessenheim.
Elle sera donnée par Claire Sergeant, chercheuse dans l’équipe Radioactivité et Environnement au Laboratoire de Physique des 2 Infinis Bordeaux (ancien Centre d’Etudes Nucléaires de Bordeaux-Gradignan).
Résumé de la conférence :
On sait que la vie est présente dans tous les environnements, y compris extrêmes en termes de température, de pression, d’acidité ou basicité, de présence de toxiques, de métaux et même de radioactivité. La capacité à résister aux rayonnements ionisants a été décrite chez plusieurs espèces bactériennes, phylogénétiquement éloignées, affiliées à plusieurs genres. Parmi les plus résistantes, des espèces comme Deinococcus radiodurans peuvent survivre à des doses allant jusqu’à 15 000 Gray. Divers mécanismes sont utilisés par les bactéries pour résister à la présence d’éléments toxiques tels que métaux et radioéléments : biosorption, bioaccumulation, bioréduction, biominéralisation ; ce qui peut leur conférer des propriétés permettant de décontaminer des milieux environnementaux. En m’appuyant sur les diverses études menées par mon équipe depuis une vingtaine d’années, je présenterai le rôle que peuvent jouer certaines bactéries dans les environnements contaminés.
Cette conférence aura lieu par visioconférence uniquement.
Attention, inscriptions obligatoires !
Afin de pouvoir vous accueillir au mieux, merci de vous inscrire ici avant le 12 juin 2022. Le lien visio sera envoyé aux inscrits le matin de la conférence. Merci de votre compréhension.
Conférence - « Quel rôle pour les bactéries dans des environnements contaminés par des radioéléments ? »
Informations pratiques
-
Lieu
Uniquement en visioconférence
Itinéraire
-